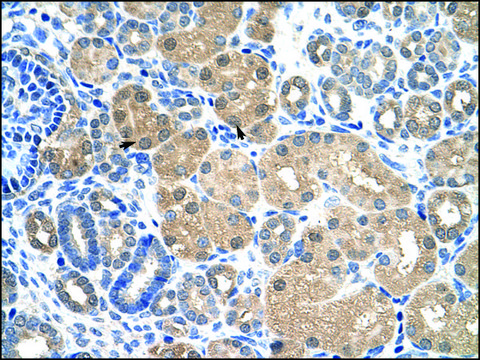
Anti-KEAP1 antibody produced in rabbit IgG fraction of antiserum

Anti-KEAP1 antibody produced in rabbit
Synonym(s):
Anti-Cytosolic inhibitor of Nrf2 antibody produced in rabbit, Anti-Kelch-like ECH-associated protein 1 antibody produced in rabbit, Anti-Kelch-like protein 19 antibody produced in rabbit
Products
Product Category
Brand
Biological Source
Clonality
Gene Alias
Physical Form
Product Line
Antibody Form
Research Area
Conjugate
Quality Segment
Post Translational Modification
Species Reactivity
Technique
Showing 1-3 of 3
Compare
Product Number
Description
Pricing